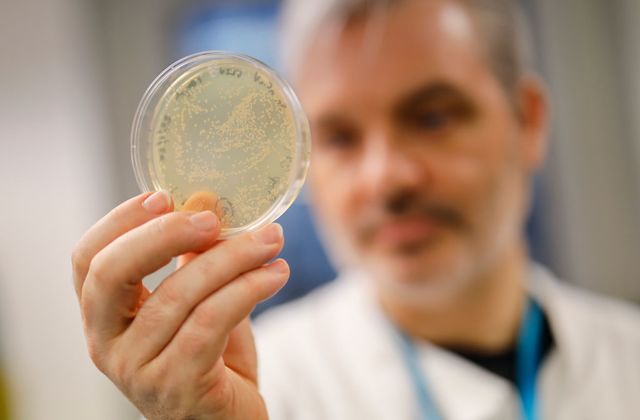

(John Solomon) The Wuhan lab leak theory, which AP claimed to debunk and Facebook censored, got a moderate probability rating by U.S. intel, while natural evolution got a “low” confidence rating.
by John Solomon, August 30th, 2021
The U.S. intelligence community’s latest report on the origins of COVID-19 could not determine whether the virus was leaked from a Chinese lab or evolved in nature. But its inconclusive determination conclusively illustrated one thing: News media and Big Tech censorship harmed Americans’ ability to have an informed debate.
For months, news media giants panned as “debunked” or “conspiracy theories” the claims that the coronavirus emanated from a Wuhan virology lab, while social media giants censored posts, even though the information often came from American government officials or Chinese scientists with access to credible information.
But when the U.S. intelligence community issued its verdict last week — at the request of President Joe Biden — the lab leak theory first offered by former President Donald Trump and his team got a higher rating of “moderate confidence” from one agency while the natural origins theory got a “low confidence” rating from multiple agencies.
In other words, the lab leak theory was as credible, if not more, than the one official Washington and elitist news and social media gatekeepers had declared unequivocally to be true for most of 2020 and early 2021.
“All agencies assess that two hypotheses are plausible: natural exposure to an infected animal and a laboratory-associated incident,” the report declared.
“The IC judges they will be unable to provide a more definitive explanation for the origin of COVID-19 unless new information allows them to determine the specific pathway for initial natural contact with an animal or to determine that a laboratory in Wuhan was handling SARSCoV-2 or a close progenitor virus before COVID-19 emerged,” it added.
You can read the assessment here:
The fact that both theories remain viable in August 2021 is the ultimate verdict against the censorship that kept the lab leak information from breathing during the pandemic debate that raged for almost a year.
Just how extensive was the censorship?
Well, one of the world’s largest and most influential news organizations, the Associated Press, declared the lab leak theory and Trump’s take on it as a “debunked” “falsehood” late last year, at a time when U.S. intelligence was receiving fresh evidence the lab leak theory was credible.
“Social media users and fringe websites weaved together a conspiracy theory that the virus was leaked — either accidentally or intentionally — from a lab in Wuhan, China, before the World Health Organization declared COVID-19 a pandemic in March,” the AP wrote on Dec. 17. “The falsehood was espoused by elected officials, including Trump.”
That story has not been appended with a correction.
Some of the world’s top scientists signed a letter published in the Lancet medical journal in February 2020 declaring unequivocally COVID-19 was naturally evolving. “We stand together to strongly condemn conspiracy theories suggesting that COVID-19 does not have a natural origin,” they wrote. A year later, some backed away from the claim.
Likewise, Facebook censored or flagged numerous stories from media organization like Just the News and the New York Post that discussed the lab leak theory over many months.
Facebook did an about-face in May after months of censorship and declared it would no longer flag or censor content that talked about the virus being potentially man-made. It was then revealed that Facebook’s fact-checkers were using as a source to debunk the lab theory a scientist who helped fund the Wuhan lab in question.
The biggest lesson from the COVID-19 origins brouhaha, free-speech and scientific freedom advocates say, is that censoring debate only harms those the censors often claim they are protecting.
“That’s the danger of trying to ban the discussion of some hypotheses. What if the hypothesis you ban turns out to be the correct one?” Paul Graham, the popular English-born, American computer scientist, tweeted recently.
Organic Lion’s Mane Mushroom, proven to grow new brain cells and synapses. Guard against Alzheimer’s, dementia, and mental decline. Save 10% and get free shipping with a subscription!“I can feel my mind getting sharper with Lion’s Mane. I put it in my coffee.”
Get your Lion’s Mane from Ascent Nutrition, one of the most pure and potent in the industry.
About The Author
John Solomon is an award-winning investigative journalist, author and digital media entrepreneur who serves as Chief Executive Officer and Editor in Chief of Just the News. Before founding Just the News, Solomon played key reporting and executive roles at some of America’s most important journalism institutions, such as The Associated Press, The Washington Post, The Washington Times, Newsweek, The Daily Beast and The Hill.
Stillness in the Storm Editor: Why did we post this?
The news is important to all people because it is where we come to know new things about the world, which leads to the development of more life goals that lead to life wisdom. The news also serves as a social connection tool, as we tend to relate to those who know about and believe the things we do. With the power of an open truth-seeking mind in hand, the individual can grow wise and the collective can prosper.
– Justin
Not sure how to make sense of this? Want to learn how to discern like a pro? Read this essential guide to discernment, analysis of claims, and understanding the truth in a world of deception: 4 Key Steps of Discernment – Advanced Truth-Seeking Tools.
Stillness in the Storm Editor’s note: Did you find a spelling error or grammatical mistake? Send an email to [email protected], with the error and suggested correction, along with the headline and url. Do you think this article needs an update? Or do you just have some feedback? Send us an email at [email protected]. Thank you for reading.
Source:
Support our work! (Avoid Big Tech PayPal and Patreon)DIRECT DONATION

Leave a Reply